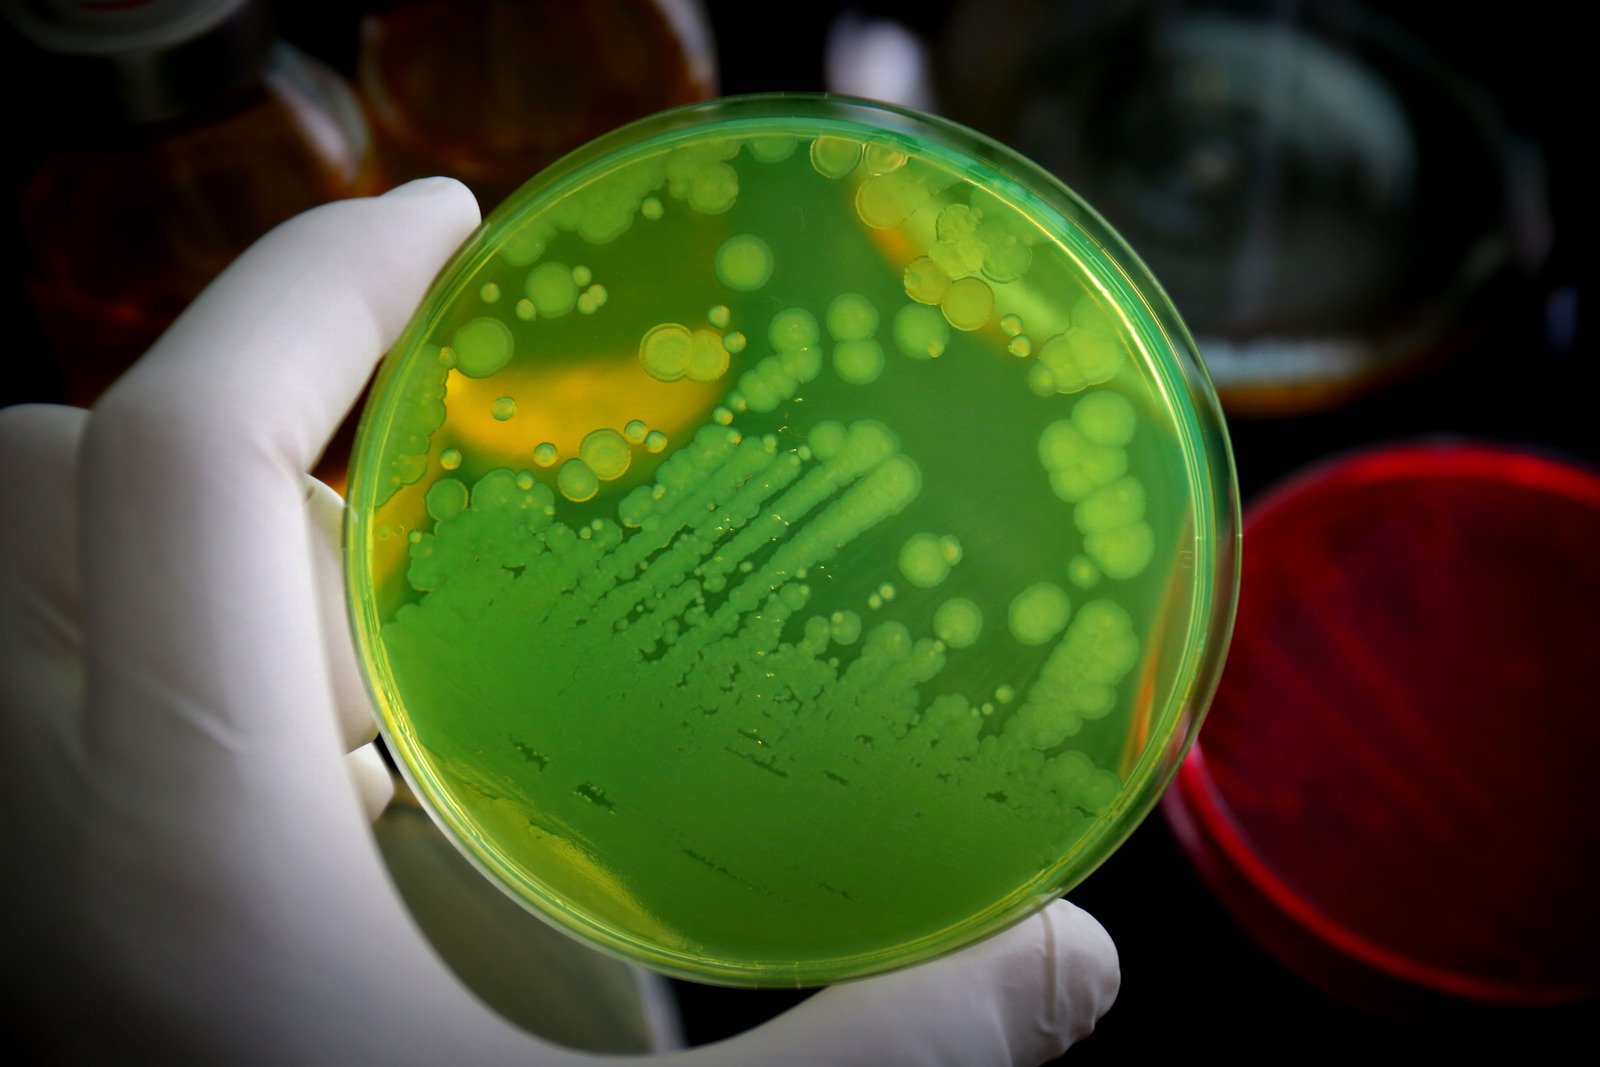
슈도모나스 감염

슈도모나스 감염(Pseudomonas Infection)에 대한 정보
슈도모나스 감염은 주로 슈도모나스 아에루기노사(Pseudomonas aeruginosa)라는 박테리아에 의해 발생하는 감염입니다.
이 박테리아는 환경 내에서 흔히 발견되며, 특히 병원 내에서 감염을 유발하는 주요한 병원균 중 하나입니다.
슈도모나스 감염의 특징
감염 부위: 피부, 폐, 귀, 눈, 요로 등 다양한 부위에 감염을 일으킬 수 있습니다.
면역력 저하자에 위험: 특히 면역 체계가 약화된 사람들, 만성 질환을 가진 사람들, 화상 환자, 병원에 입원한 환자들에게서 더 흔히 발생합니다.
슈도모나스 감염의 원인
슈도모나스 감염은 주로 슈도모나스 아에루기노사(Pseudomonas aeruginosa)라는 박테리아에 의해 발생합니다.
이 박테리아는 자연 환경뿐만 아니라 병원과 같은 의료 환경에서도 널리 분포하는데, 특히 면역력이 약화된 사람들에게 감염을 일으키는 경우가 많습니다.
감염 경로
환경 노출: 슈도모나스는 흙, 물, 식물 등 다양한 자연 환경에 존재합니다. 이러한 환경에 노출되었을 때 감염이 발생할 수 있습니다.
병원 내 감염: 병원 내에서 사용되는 의료 기기나 물품을 통해 감염되는 경우가 있습니다.
이는 특히 수술 후 환자, 중환자실 환자, 화상 환자 등 면역력이 약한 환자들에게서 더 흔합니다.
직접 접촉: 감염된 사람이나 동물, 오염된 물체와의 직접 접촉을 통해 전파될 수 있습니다.
위험 요소
면역 체계 약화: HIV/AIDS, 암, 당뇨병, 만성 폐 질환 등으로 인해 면역 체계가 약화된 사람들이 더 취약합니다.
병원 환경: 특히 중환자실, 수술실 등의 병원 환경에서 더 흔히 발생합니다.
장기간의 항생제 사용: 항생제를 장기간 사용하는 경우 박테리아에 대한 내성이 생길 수 있으며, 이로 인해 슈도모나스 감염 위험이 증가할 수 있습니다.
증상
피부 감염: 발적, 부기, 통증, 농양 형성
호흡기 감염: 기침, 호흡 곤란, 발열
요로 감염: 배뇨 시 통증, 빈번한 배뇨, 발열
귀 감염: 통증, 청력 감소, 분비물
슈도모나스 감염의 치료
슈도모나스 감염의 치료는 일반적으로 항생제를 사용하여 박테리아를 퇴치하는 데 초점을 맞춥니다. 그러나 슈도모나스 아에루기노사는 특정 항생제에 대해 내성을 보일 수 있기 때문에, 치료는 종종 복잡할 수 있습니다.
항생제 치료
적절한 항생제 선택: 감염이 의심되는 경우, 일반적으로 박테리아에 대한 감수성 테스트를 실시하여 적절한 항생제를 결정합니다.
복합 치료: 때때로, 여러 항생제를 병행하여 사용하여 감염에 더 효과적으로 대응하기도 합니다.
장기간 치료: 슈도모나스 감염은 다른 박테리아 감염보다 치료 기간이 길어질 수 있습니다.
지지적 치료
수분 및 영양 섭취 유지: 충분한 수분과 영양 섭취를 통해 환자의 전반적인 건강 상태를 지원합니다.
증상 완화: 발열, 통증 등의 증상을 완화하기 위한 대증 치료가 필요할 수 있습니다.
감염 관리
감염 확산 방지: 특히 병원 환경에서는 감염의 확산을 방지하기 위한 조치를 취합니다.
면역 체계 강화: 면역 체계를 강화하기 위한 일반적인 건강 관리가 중요합니다.
예방 및 모니터링
반복 감염 예방: 슈도모나스 감염은 재발할 수 있으므로, 예방 및 지속적인 모니터링이 필요합니다.
슈도모나스 감염의 치료는 감염의 위치, 환자의 건강 상태, 박테리아의 항생제 내성 패턴에 따라 달라질 수 있습니다. 따라서, 의료 전문가의 정확한 진단과 지시에 따라 치료를 진행하는 것이 중요합니다.
예방
위생 관리: 철저한 손 씻기와 개인 위생 관리가 중요합니다.
병원 내 감염 예방: 병원 내에서는 적절한 소독과 감염 관리 프로토콜을 준수하는 것이 중요합니다.
주의사항
항생제 내성: 슈도모나스는 여러 항생제에 대한 내성을 가질 수 있으므로, 감염 시 정확한 항생제 감수성 검사가 필요합니다.
면역력 강화: 면역 체계를 강화하는 것이 감염 예방에 도움이 됩니다.
슈도모나스 감염은 치료가 복잡할 수 있으므로, 의심되는 증상이 나타날 경우 즉시 의료 전문가의 진료를 받는 것이 중요합니다.
'의학에 대해서' 카테고리의 다른 글
| 안면 홍조증(Hot Flush)에 대한 이해 (0) | 2024.01.16 |
|---|---|
| 습진(Eczema) 이해와 관리 (0) | 2024.01.16 |
| 수족구병(Hand, Foot, and Mouth Disease)에 대한 정보 (0) | 2024.01.15 |
| 수부 습진(Hand Eczema)에 대한 정보 (0) | 2024.01.14 |
| 수두(Varicella, Chickenpox)에 대한 정보 (0) | 2024.01.14 |
댓글